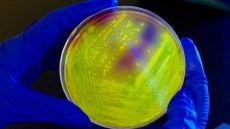
Heavy Use Of Antibiotics In Nursing Homes Equates To Risk For Residents: Study

OTTAWA — Call it the Mike Duffy question.
When Canadians receive their census questionnaire next year, they'll be asked to fill out the address of their "secondary residence," if they happen to have one and are at that location on census day.
"A secondary residence" could be, "for example, a cottage," the form reads.
It's the same question that Statistics Canada asks every five years: Tell us where you live and whether this is your usual place of residence. Statcan says the questions were the same in 2011.
All of which means the agency has a better idea of what constitutes a secondary residence than the Senate does — a question central to the ongoing controversy over housing expenses and the upper chamber.
The census question is meant to ensure that respondents aren't counted more than once. Such a mistake, multiplied millions of times over, could throw off population counts that governments and private businesses use when designing programs or planning projects.
It's up to the person filling out the form to determine their "usual place of residence," said spokeswoman Nadine Lacroix. She said Statistics Canada doesn't capture data on the number of people on census day who are "temporarily staying at a secondary residence."
This particular question was tested between June 2013, just after the scandal over Duffy's housing claims were referred to the RCMP, and May 2014, after the RCMP confirmed Nigel Wright, Prime Minister Stephen Harper's former chief of staff, wouldn't face criminal charges for giving Duffy money to cover the repayment of the senator's questionable housing claims.
The testing didn't turn up any problems that required rewording of the residence question so people could understand it better, Statistics Canada says.
That may be cold comfort to the eight senators who are in trouble over their housing claims, including Duffy, Patrick Brazeau and Mac Harb, as well as five others who were referred to the RCMP after last month's Senate spending audit.
In each case, senators have been accused of not spending enough time at their primary residence, which would make them ineligible for an annual housing allowance.
What exactly constitutes a primary and secondary residence has become a key component of Duffy's criminal trial, where he has pleaded not guilty to all 31 charges related to his Senate spending.
Court has heard that Duffy started renovating his Prince Edward Island cottage after being appointed a senator from P.E.I.; the work was focused on making the structure a year-round home.
One witness who did work on the building, Clifford Dollar, testified that the Cavendish, P.E.I., cottage didn't have running water in the winter and was sometimes so snowed in that Duffy wasn't able to walk to the front door.
The Crown alleges Duffy lived primarily at a home in an Ottawa suburb that he had owned for years, but identified Cavendish as his primary residence in order to claim about $90,000 in housing and meal expenses through the Senate.
Duffy's defence lawyer has said Duffy followed the Senate's rules when he filed the claims, and has attacked the rules themselves as problematic and vague.